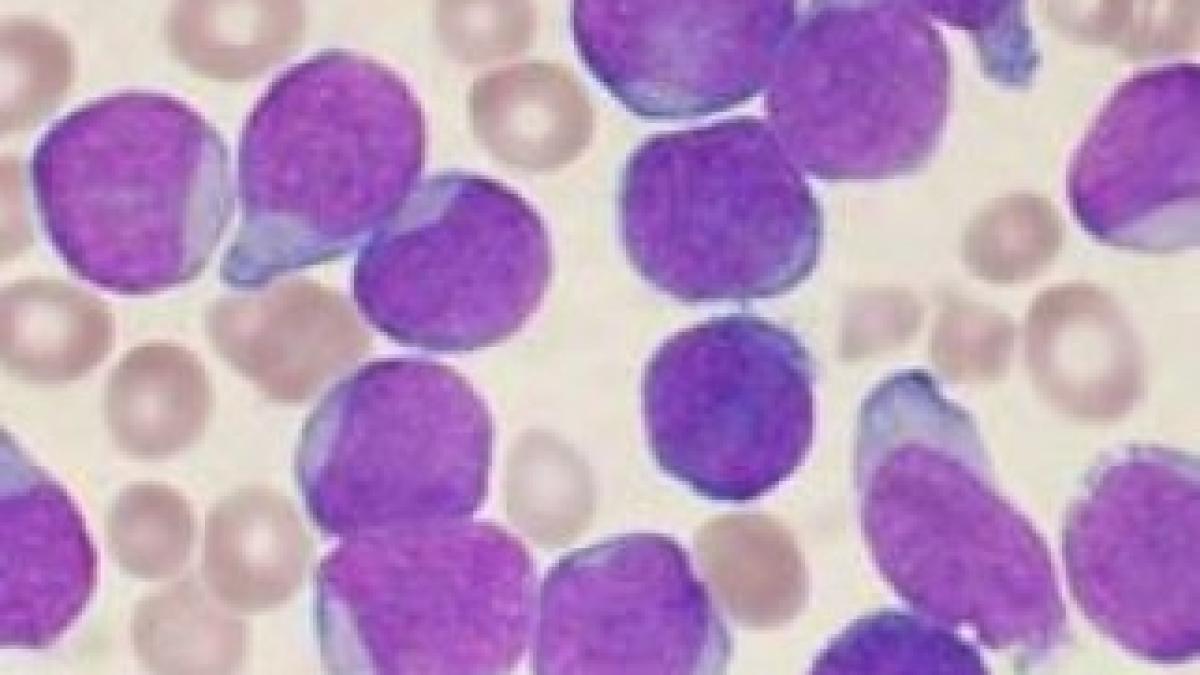
leucemie

Un tratament inedit a stimulat atacul imun selectiv asupra celulelor leucemice la pacienții post-transplant. Pacienții cu leucemie limfocitară cronică avansată (LLC) de multe ori primesc transplanturi de la donatori, ce "repornesc" în mod eficient propriile lor sisteme de apărare imunitară, care apoi atacă și, potențial, vindecă bolile greu de tratat.
Eliza Cristina Cioacă

Cu toate acestea, la acești pacienți există o rată mare de recidiv, și transplantul de celule ale sistemului imunitar poate afecta, de asemenea, țesuturile normale, care provoacă boala grefă-contra-gazdă.
Acum, oamenii de știință de la Institutul de Cancer Dana-Farber, afiliat Hardvard au comunicat în Journal of Clinical Investigation că au observat un răspuns imunitar mai puternic și selectiv la unii pacienți care au primit la scurt timp după transplant mai multe doze de vaccin „personalizate”, compuse din propriile lor celule leucemice inactive în combinație cu un imunostimulator (GM-CSF). Astfel, vaccinul a amplificat abilitatea sistemului imunitar transplantat să atace cancerul - cunoscut sub numele de (GVL) sau efectul grefă-contra-leucemie.
Există puține opțiuni de tratament pentru leucemia limfociatară cronică avansată. Transplanturile standard, care implică doze puternice de chimioterapie pre-transplant pentru a distruge cât mai mult din leucemie pe cât este posibil, s-au dovedit a fi prea toxice pentru pacienții în vârstă și cei cu boli co-existente.
Pentru a crea vaccinul, cercetătorii au amestecat celulele canceroase iradiate ale pacienților cu celule care produc GM-CSF și apoi le-au injectat înapoi în pacient. Combinația stârnește un răspuns puternic de celulele T ale sistemului imunitar și antigenii distinctivi a celulelor leucemice injectate direcționează celulele T pentru a ataca celulele leucemice similare oriunde acestea sunt prezente în organism.
Rezultatele sprijină siguranța și activitatea biologică a întregului proces de vaccinare a celulelor tumorale în afecțiuni maligne hematologice, au declarat autorii, și, oferind vaccinul la scurt timp după transplant, poate fi critic în eficacitatea acestuia.
Cu toate acestea, autorii au concluzionat că studii viitoare aleatorii, în grupuri mai mari de pacienți, vor fi necesare pentru a determina dacă această strategie „se va traduce într-un beneficiu clinic valabil și pentru pacienții cu leucemie limfocitară cronică avansată”.
Primul autor al raportului este Ute E. Burkhardt pentru Institutul Dana-Farber. Aici găsiți întreg articolul, realizat de Richard Saltus pentru hardvard.edu.